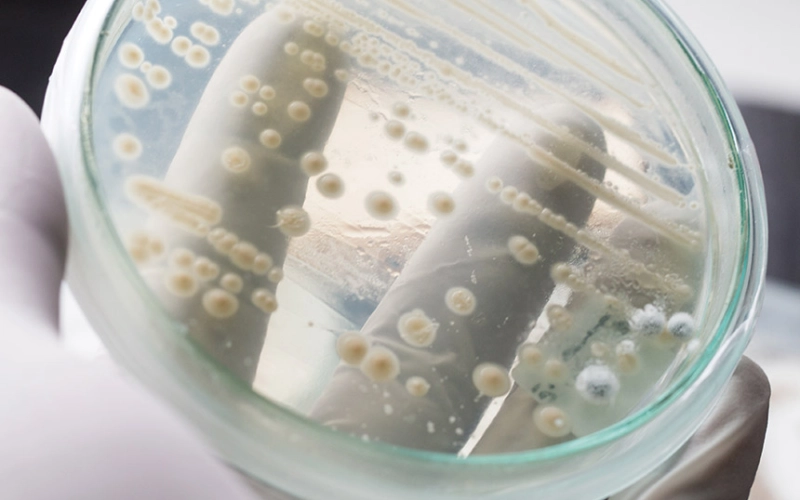
Преимущества пробиотиков в процессах гранулирования кормов: устойчивость и эффективность.

Чт, 26 февраля
Разница между 2,5% и 3,2% кажется минимальной — всего 0,7%. Многие берут привычную упаковку молока и не задумываются, влияет ли эта цифра на вкус, пользу и кулинарию. На самом деле жирность меняет текстуру, насыщенность и даже то, как молоко ведет себя в кофе или тесте.